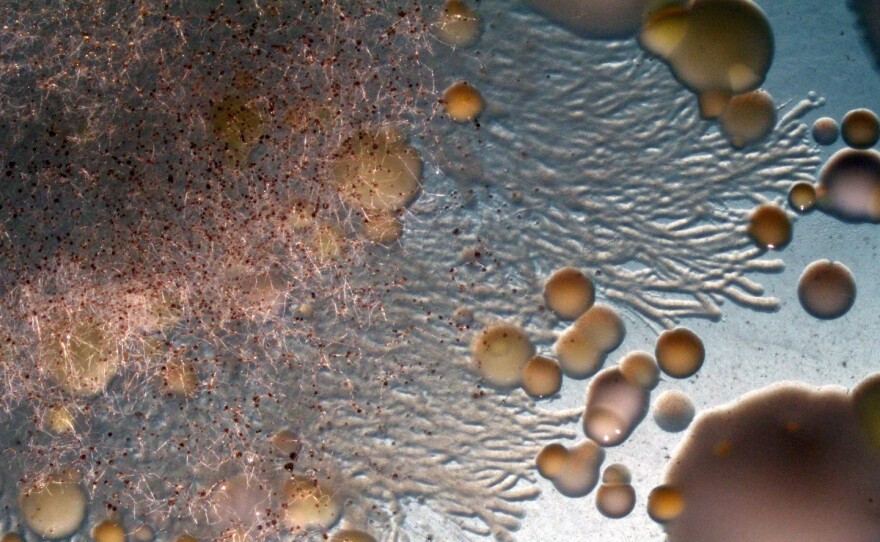

It was the tiny streams of slime that stood out.
As a microbiologist who studies the rinds of cheeses like Stilton, Gruyere and Taleggio, Benjamin Wolfe had done plenty of experiments on bacteria, yeast and mold. But he'd never seen anything like this.
He wasn't actually running a lab test when he noticed those slimy streams — he was working with a photographer to document the microbes of a Saint-Nectaire rind. He expected to show the photographer what he normally saw from cheese microbes: fungal molds that branched out in many directions, like a plants' roots, and bacterial colonies camped out in dots and blobs. But there was something else, too: little rivulets running along the branches of a swath of fungus.
Maybe swimming bacteria were creating the streams, but he couldn't be sure. Inspired by the photo shoot, Wolfe, an assistant professor at Tufts University, went back to his cheese rinds with new questions. What, exactly, was traveling along the fungus, and how was it moving?
He'd read about bacteria moving along fungi in soil. The microscopic, branched tendrils that fungi use to bring in nutrients — their hyphae — functioned as a specialized microbial highway. "Bacteria can swim through liquids, and the fungi, these hyphae, have a thin layer of liquid on the outside of them," Wolfe says. Soil bacteria were known to hop into this lazy river for travel.
In the fungus he saw, even a tiny channel of water outside fungal branches would leave a bacterium plenty of room to swim. But it was also possible that he'd just seen bacteria hitching a ride as the fungus grew, instead of swimming on their own.
So he and his students scraped samples off cheese rinds, and chose microbes for experiments, which they published recently in Nature Communications. They picked a swimming bacteria, and a few molds that grew at different speeds, hoping to see if the bacteria was moving, or if the fungi did all the pushing. One mold grew quickly and spread out wide, like a microbial Los Angeles, while another grew slowly, knitting itself into dense networks, more like a fungal Tokyo.
These are cheese rind microbes, so many bring a special flavor to the table. Their choice of bacteria, Serratia proteamaculans, gives a cheese a nice note of cooked cabbage. The slow-growing fungal mold, a strain of Penicillium, tastes earthy, like mushrooms, with a hint of damp basement, Wolfe says.
Another mold they studied, Galactomyces geotrichum, contributes a strong, unique flavor profile suited for stinky cheese lovers. "The best way to describe it is sweet, buttery flatulence," Wolfe says. He meant that as a compliment.
Sure enough, when Wolfe and his students left bacteria to grow alongside fungal molds, the colonies spread farther than bacteria alone. As the mold branched outward, it seemed, it gave nearby bacteria a boost. And at closer zoom, the bacteria were clearly swimming along the hyphae, just like the streams Wolfe noticed during that first surprising photo shoot.

From a cheese-making perspective, it's a really nice idea that fungal molds would help bacteria spread out and grow. Both entities imbue their surroundings with different flavors, so their intermingling creates a complex, tasty cheese. But from a microbial standpoint, it doesn't make perfect sense that fungus and bacteria would cooperate.
That's because all these microbes need the same ingredients to survive — water and nutrients — and when resources are scarce, they've got tricks for making sure the competition isn't friendly. Fungal molds create chemicals specialized to burst bacteria open, which we've co-opted for antibiotics like penicillin. Bacteria have specialized enzymes, called chitinases, that liquify fungi, reducing them to a slurpable smoothie of carbon and nitrogen. "People have looked at fungal hyphae and bacteria just as antagonists," says Lukas Wick, a microbiologist at the Helmholtz Centre for Environmental Research. "And this is certainly part of the story, but it's a really complex story."
Despite those unfriendly adaptations, bacteria stand to gain a lot from fungal networks. Fungi pump water and nutrients around their hyphae, so any bacteria along for the ride also has access to those resources."They are a logistic network themselves — it's a type of supply chain," says Wick. For a bacterium, hyphae is the opposite of a lonely state highway that stretches for miles without a gas station or drive-thru in sight.

Not all bacteria can swim, so the fungal network can only take some bacteria so far. And unfortunately, many toxic bacteria can hop onto the hyphae highway. E. coli grows better in foods that contain certain fungi. Listeria, which can infect the cheeses Wolfe studies, is also known to travel via fungal network.
But ideally, as the picture of how specific fungi affect certain bacteria gets clearer, cheese mongers will be able to tweak the microbial communities of their cheese rinds to maximize precise flavors and minimize contamination. One day, cheese makers might cultivate a fungus that deters dangerous bacteria, ferrying only the flavorful microbes along.
Copyright 2023 NPR. To see more, visit https://www.npr.org.